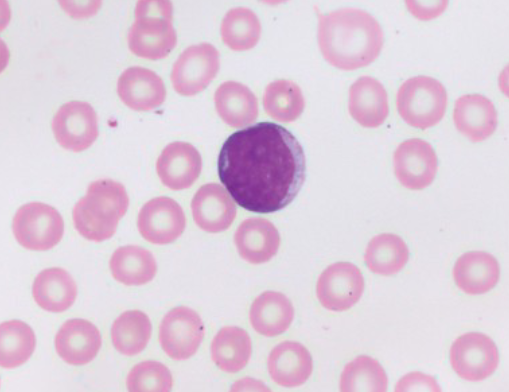
<p>What WBC precursor is this?</p>
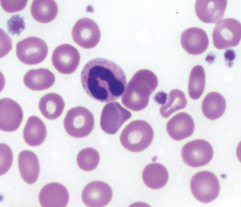
<p>Which WBC is this?</p>
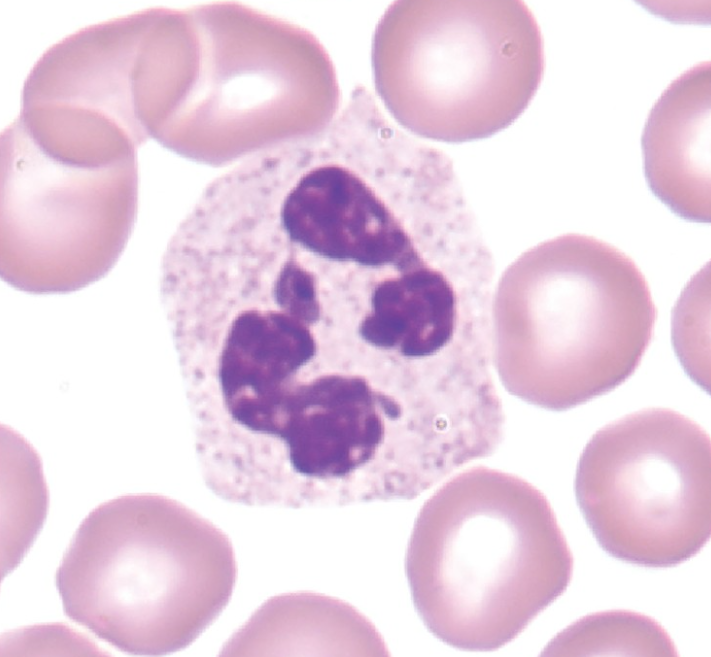
<p>Which WBC is this?</p>
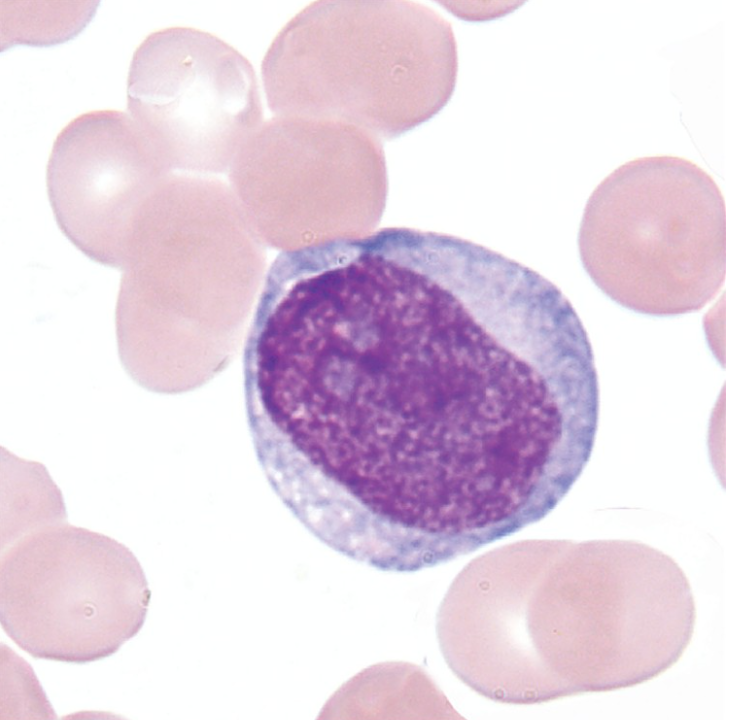
<p>What WBC precursor is this?</p>
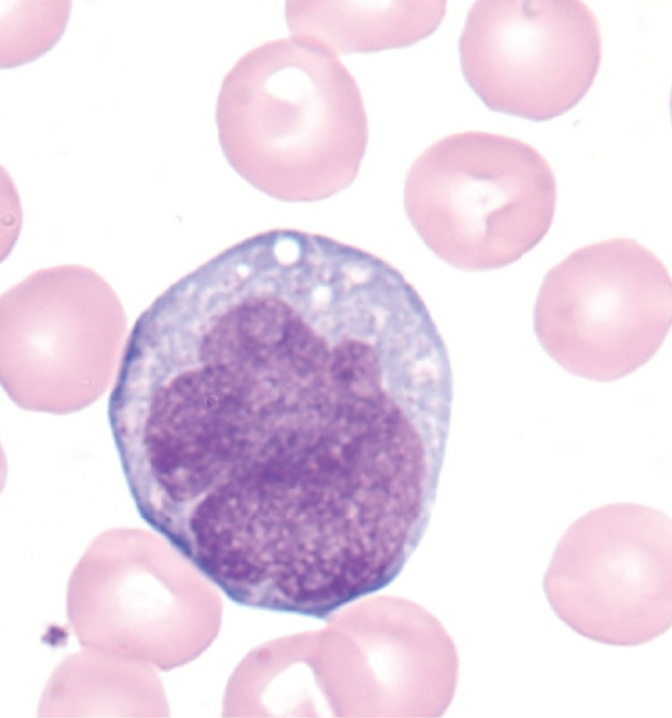
<p>What WBC precursor is this?</p>
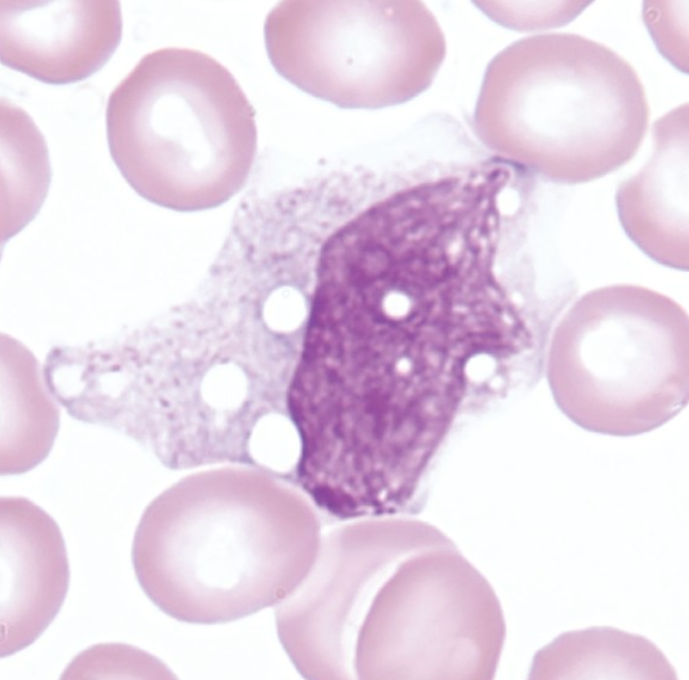
<p>What WBC is this?</p>
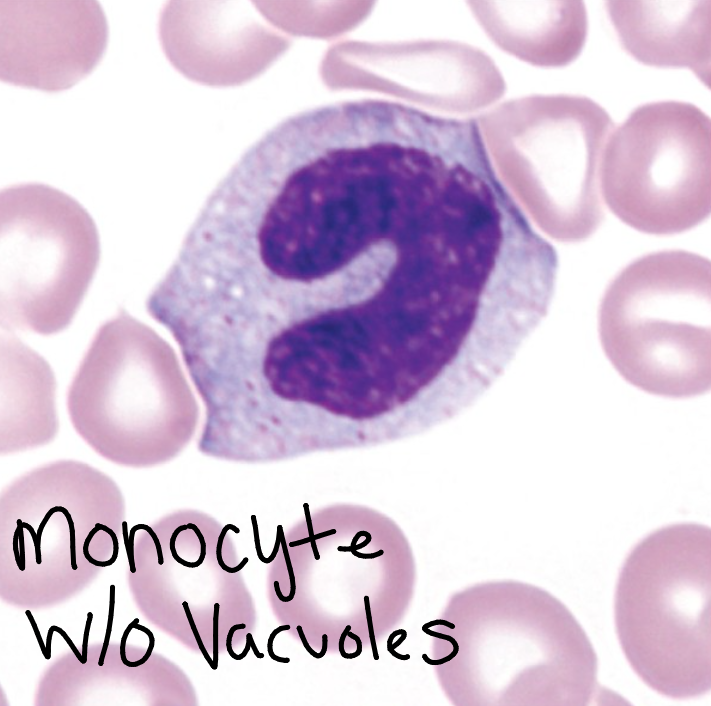
<p>Monocyte</p><p>12-20 micrometers, variable nucleus, may be round, horseshoe shaped, or kidney shaped; often has fold producing “brain-like convolutions”, lacy chromatin, Blue-gray cytoplasm; may have psuedopods, many fine granules frequently giving the appearance of ground glass. May or may not have vacuoles, N:C ratio variable. CD 33, 13, 14</p>
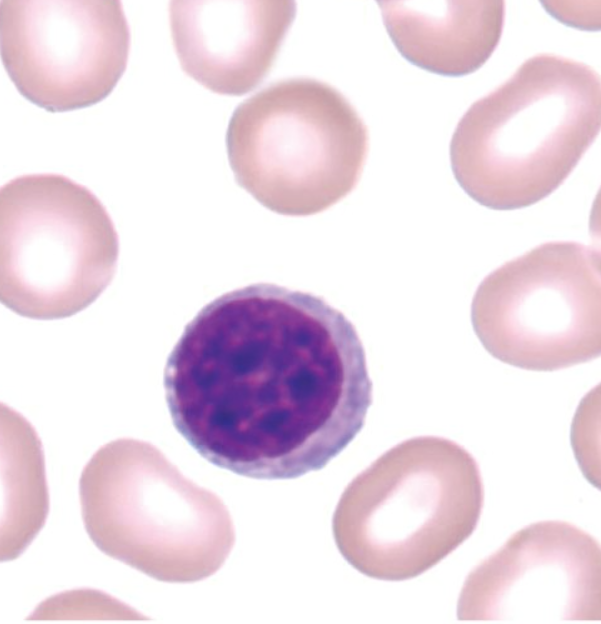
<p>What WBC is this?</p>
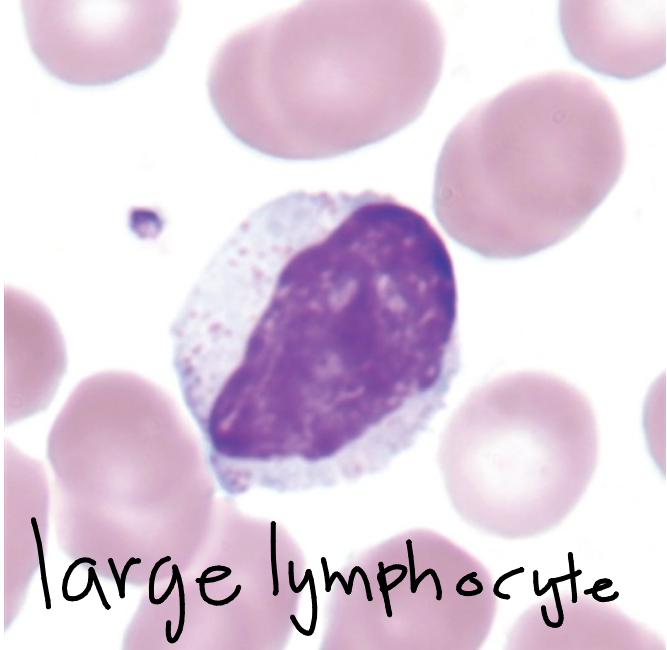
<p>Lymphocyte</p><p>7-18 micrometers, round to oval, may be slightly indented nucleus, occasional nucleoli, condensed, clumped chromatin, scant to moderate, sky blue, vacuoles may be present, NO granules in small lymphocyte; may be a few azurophilic in larger lymphocytes, N:C 5:1-2</p>
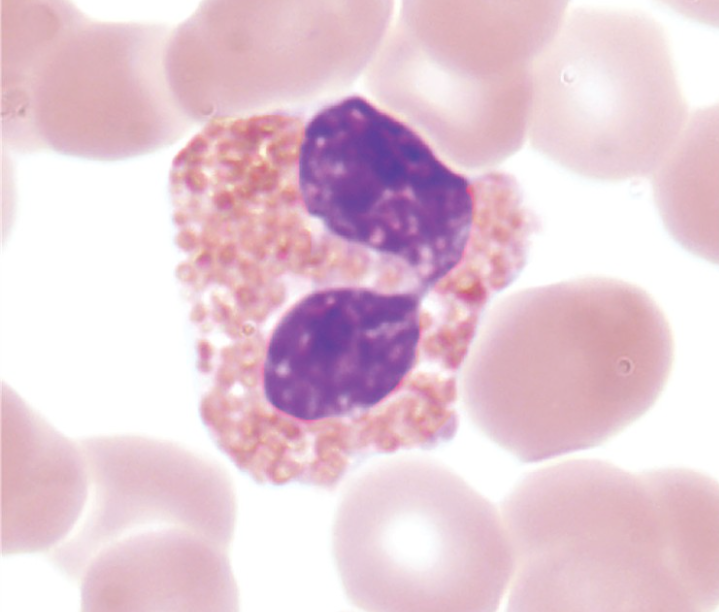
<p>Which WBC is this?</p>
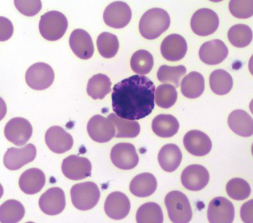
<p>What WBC is this?</p>
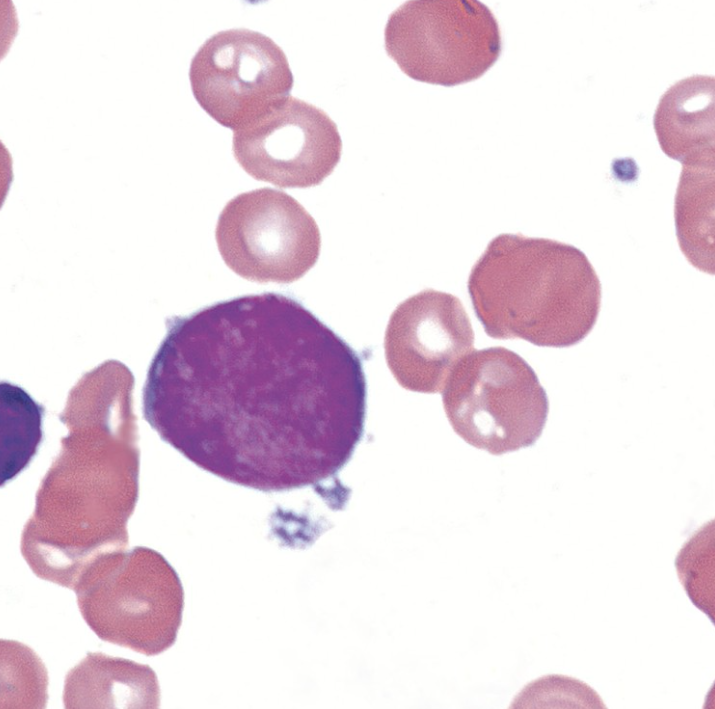
<p>What cell is this? </p>

1/20
Looks like no tags are added yet.
Name | Mastery | Learn | Test | Matching | Spaced | Call with Kai |
|---|
No analytics yet
Send a link to your students to track their progress
What WBC precursor is this?
Myeloblast
14-20 micrometers, N:C 6:1, indented nucleus & thin chromatin strands, moderate blue cytoplasm usually w/o granules, 2-5 nucleoli. CD markers 45, 38, 34, 33, 13, HLA-DR


What WBC precursor is this?
Promyelocyte
15-22 micrometers, N:C 3:1, oval, round, or eccentric nucleus, light red-purple chromatin, moderate blue cytoplasm with fine to large blue-red azurophilic granules, 1-3 prominent nucleoli. CD markers 45, 33, 13, 15.

What WBC precursor is this?
Myelocyte
10-18 micrometers, N:C 2:1, red-purple, oval, indented, denser nucleus. Has dusty, fine, red-blue granules. Last stage to divide. CD markers 45, 33, 13, 15, 11b/11c

What WBC precursor is this?
Metamyelocyte
10-15 micrometers, N:C 1:1, kidney bean nucleus (no nucleoli), pale blue to pinkish tan with moderate granules, CD markers same as myelocyte 45, 33, 13, 15, 11b/11c
Which WBC is this?
Band
9-15 micrometers, N:C Cytoplasm predominates, C or S-shaped nucleus with no filaments, brown-pink cytoplasm with fine specific granules, seen in a normal peripheral smear. CD markers 45, 13, 15, 11b/11c
Which WBC is this?
Segmented Neutrophil
9-15 micrometers, 2-5 lobes of nucleus connected by filaments without visual chromatin patterns, pale lilac cytoplasm with many fine secondary dust-like granules, seen in normal peripheral smear
What WBC precursor is this?
Monoblast
12-18 micrometers, Nucleus: Round to oval, may be irregularly shaped, 1-2 nucleoli and fine chromatin. Light blue to gray cytoplasm, NO granules, N:C 4:1
What WBC precursor is this?
Promonocyte
12-20 micrometers, irregularly shaped nucleus may have “brain-like convolutions”, fine to lacy chromatin; gray-blue cytoplasm, fine azurophilic cytoplasm, N:C 2:1-3:1
What WBC is this?
Monocyte
12-20 micrometers, variable nucleus, may be round, horseshoe shaped, or kidney shaped; often has fold producing “brain-like convolutions”, lacy chromatin, Blue-gray cytoplasm; may have psuedopods, many fine granules frequently giving the appearance of ground glass. May or may not have vacuoles, N:C ratio variable. CD 33, 13, 14

What WBC precursor is this?
Lymphoblast
10-20 micrometers, round to oval nucleus, 1+ nucleoli, fine evenly stained chromatin, Scant cytoplasm; slightly to moderately basophilic, NO granules, N:C 7:1-4:1

What WBC precursor is this?
Prolymphocyte
9-18 micrometers, round or indented nucleus, 0-1 large prominent nucleolus, slightly clumped chromatin, light blue cytoplasm, NO granules, N:C 3:1-4:1
What WBC is this?
Lymphocyte
7-18 micrometers, round to oval, may be slightly indented nucleus, occasional nucleoli, condensed, clumped chromatin, scant to moderate, sky blue, vacuoles may be present, NO granules in small lymphocyte; may be a few azurophilic in larger lymphocytes, N:C 5:1-2

What WBC precursor is this?
Eosinophilic myelocyte
12-18 micrometers, round to oval nucleus may have one flattened side, nucleoli usually not visible, coarse and more condensed chromatin, colorless to pink cytoplasm. Primary granules: few to moderate, Secondary granules: variable number; pale orange to dark orange; round; appear refractile. N:C 2:1-1:1

What WBC precursor is this?
Eosinophilic metamyelocyte
10-15 micrometers, indented, kidney-bean shape nucleus, nucleoli not visible, coarse, clumped chromatin; colorless, cream colored cytoplasm. Primary granules: few, Secondary granules: many pale orange to dark orange; appear refractile. N:C 1.5:1

What WBC precursor is this?
Eosinophilic band
10-15 micrometers, nucleus: constricted but no threadlike filament; indentation is more than 50% of the width of a hypothetical round nucleus. Nucleoli not visible, chromatin coarse and clumped, colorless/cream colored cytoplasm. Primary granules: few, Secondary granuales: abundant pale to dark orange; appear refractile. N:C ratio cytoplasm predominates
Which WBC is this?
Eosinophil
10-16 micrometers, N:C is barely 1:2, eccentric usually bilobed, large red-orange specific granules containing histamine with orange-pink cytoplasm, response to parasitic, allergic, and hyper sensitive reactions
What WBC is this?
Basophil
10-14 micrometers, coarse, clumped bilobed nucleus with large dark granules, contain histamine and heparin, respond in hypersensitive reactions
(maturation parallels neutrophil; immature basophils are very rare)

What cell is this?
Plasma cell
8-20 micrometers, round to oval eccentric nucleus, no nucleoli, coarse chromatin, deeply basophilic cytoplasm often with perinuclear clear zone,
NO granules, may or may not have vacuoles, N:C 2:1-1:1
What cell is this?
Megakaryoblast (MK-I)
12-24 micrometers, round nucleus, 2-6 nucleoli, homogenous, loosely organized chromatin, basophilic cytoplasm, granules absent in wright, N:C 3:1

What cell is this?
Promegakaryocyte (MK-II)
15-40 micrometers, indented nucleus, variable nuceloli, condensed chromatin, basophilic cytoplasm, granules present, N:C 1:2

What cell is this?
Megakaryocyte (MK-III)
20-90 micrometers, nucleus 2-32 lobes (8 lobes: most common), blue to pink abundant cytoplasm, reddish blue granules few to abundant, N:C variable